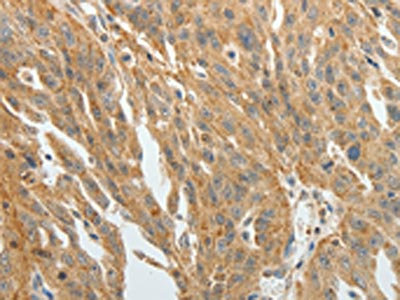

F3 Antibody
-
中文名稱(chēng):F3兔多克隆抗體
-
貨號(hào):CSB-PA981490
-
規(guī)格:¥1100
-
圖片:
-
The image on the left is immunohistochemistry of paraffin-embedded Human ovarian cancer tissue using CSB-PA981490(F3 Antibody) at dilution 1/20, on the right is treated with fusion protein. (Original magnification: ×200)
-
The image on the left is immunohistochemistry of paraffin-embedded Human thyroid cancer tissue using CSB-PA981490(F3 Antibody) at dilution 1/20, on the right is treated with fusion protein. (Original magnification: ×200)
-
-
其他:
產(chǎn)品詳情
-
Uniprot No.:
-
基因名:
-
別名:CD142 antibody; CD142 antigen antibody; Coagulation factor III (thromboplastin tissue factor) antibody; Coagulation factor III antibody; F3 antibody; FLJ17960 antibody; TF antibody; TF_HUMAN antibody; TFA antibody; Thromboplastin antibody; Tissue factor antibody
-
宿主:Rabbit
-
反應(yīng)種屬:Human
-
免疫原:Fusion protein of Human F3
-
免疫原種屬:Homo sapiens (Human)
-
標(biāo)記方式:Non-conjugated
-
抗體亞型:IgG
-
純化方式:Antigen affinity purification
-
濃度:It differs from different batches. Please contact us to confirm it.
-
保存緩沖液:-20°C, pH7.4 PBS, 0.05% NaN3, 40% Glycerol
-
產(chǎn)品提供形式:Liquid
-
應(yīng)用范圍:ELISA,IHC
-
推薦稀釋比:
Application Recommended Dilution ELISA 1:2000-1:5000 IHC 1:25-1:100 -
Protocols:
-
儲(chǔ)存條件:Upon receipt, store at -20°C or -80°C. Avoid repeated freeze.
-
貨期:Basically, we can dispatch the products out in 1-3 working days after receiving your orders. Delivery time maybe differs from different purchasing way or location, please kindly consult your local distributors for specific delivery time.
-
用途:For Research Use Only. Not for use in diagnostic or therapeutic procedures.
相關(guān)產(chǎn)品
靶點(diǎn)詳情
-
功能:Initiates blood coagulation by forming a complex with circulating factor VII or VIIa. The [TF:VIIa] complex activates factors IX or X by specific limited proteolysis. TF plays a role in normal hemostasis by initiating the cell-surface assembly and propagation of the coagulation protease cascade.
-
基因功能參考文獻(xiàn):
- TF knockout in MDA-MB-231cells reduced TF/FVIIa signaling and coagulation activity. Silencing of TF in MDA-MB-231cells decreased the release of microvesicles. PMID: 29787758
- Subjects with AG and GG genotype had significantly higher TF levels than AA genotype. GG genotype of 603A>G polymorphism augments the risk of thrombosis by 4.4 fold, thus highlighting the significance of this polymorphism in the development of DVT PMID: 29789989
- Monocyte TF may be a relevant source of TF-mediated thrombogenicity in NSCLC patients and may be associated with prognosis in NSCLC. PMID: 28419722
- plasma activity higher in women with pre-eclampsia than in those with infants small for gestational age or normal pregnancies PMID: 28521572
- The interaction between tissue factor and filamin A is dependent on the differential phosphorylation of Ser253 and Ser258. The interaction with filamin A may translocate cell surface TF to cholesterol-rich lipid rafts, increasing cell surface TF activity as well as TF incorporation and release into microvesicles. PMID: 29044292
- Our study identifies a previously undescribed role of miRNA in venous thrombosis by regulating TF expression. Therefore, restoration of miR-145 levels may serve as a promising therapeutic strategy for management of venous thrombosis PMID: 29217135
- TF(+) microvesicless released from orthotopic pancreatic tumors increase venous thrombosis in mice. PMID: 28834179
- HUVEC and adult human dermal blood endothelial cells respond similarly to TNFalpha and IL-1beta in terms of TF expression, and both are suitable models to examine cell surface TF activity and TF-positive microvesicle release in endothelial cells. PMID: 28151805
- Cell lines with intrinsically high TF expression were associated with decreased cancer stem cell activity. Knockdown of TF was associated with increased cancer stem cell activity. Overexpression of TF was associated with decreased cancer stem cell activity. Expression of TF did not affect cellular viability but may increase proliferation. PMID: 29715083
- uPAR and TF could potentially be attractive targets for molecular imaging and therapy in oral squamous cell carcinoma due to high positive expression rates and tumor-specific expression patterns. PMID: 28841839
- The highest tissue factor activity was detected in microparticles from monocytes, lower activity - in microparticles from endothelial cells and THP-1 cells, and no activity - in microparticles from platelets and granulocytes. PMID: 27926582
- These results demonstrate that procoagulant microvesicles shed by head and neck squamous cell carcinoma line (UMSCC81B) induced a procoagulant effect in HUVECs through increased clotting activity and cell membrane surface expression of TF. PMID: 27841803
- The proinflammatory cytokine IL-33 induces differential tissue factor expression and activity in monocyte subsets, as well as the release of procoagulant microvesicless. In this manner, IL-33 may contribute to the formation of a prothrombotic state characteristic for cardiovascular disease. PMID: 28492698
- Pin1 is a fast-acting enzyme which may be utilised by cells to protect the phosphorylation state of TF in activated cells prolonging TF activity and release, and therefore ensuring adequate haemostasis. PMID: 28962834
- Circulating pentraxin nCRP has little pro-angiogenic effect but when dissociated into mCRP on the surface of endothelial cells it is able to trigger potent proangiogenic effects by inducing F3-gene upregulation and TF signaling. PMID: 27808345
- In the presence of tissue factor-positive cancer cells, the CAR-modified T cells (TF-CAR T) were highly activated and showed specific cytotoxicity to TF-positive cancer cells. PMID: 28055955
- TF is an angiogenic-specific receptor and the target molecule for fVII-targeted therapeutics. PMID: 27807692
- The present study did not show significant association of TF gene -603A/G and +5466A>G polymorphisms with venous thromboembolism in malignancy, however, further larger studies including different ethnic population are needed to confirm our findings. PMID: 27685527
- It was demonstrated that the nature of the clot formed, as determined from the quartz crystal microbalance parameters, was highly dependent on the rate of clot formation resulting from the TF concentration used for activation. These parameters could also be related to physical clot characteristics such as fibrin fibre diameter and fibre density, as determined by scanning electron microscopic image analysis. PMID: 27311950
- Through induction of TF in vascular endothelial cells, IL-33 could enhance their thrombotic capacity and thereby might impact on thrombus formation in the setting of atherosclerosis. PMID: 27142573
- Tissue Factor was highly expressed in 73.6 % of osteosarcoma biopsies, and expression associated significantly with disease-free survival. PMID: 26763081
- Platelet tissue factor activity and membrane cholesterol are increased in hypercholesterolemia and normalized by rosuvastatin, but not by atorvastatin. PMID: 28142075
- the identification of platelet TF and TLR4 as regulators of the effect of E. coli O111 might represent a novel therapeutic target to reduce the devastating consequences of the hemostatic disorder during sepsis. PMID: 28957360
- A coagulation initiating pathway is revealed in which the TF-FVIIa-nascent FXa complex activates FVIII apart from thrombin feedback. PMID: 28729433
- Ticagrelor, but not clopidogrel, reduces arterial thrombosis via endothelial tissue factor suppression. Ticagrelor reduced TNF-alpha-induced TF expression via proteasomal degradation. PMID: 28028070
- The aim of this study was to evaluate the concentration of TF and its inhibitor TFPI in blood plasma, the impact of traditional and non-traditional cardiovascular risk factors on their concentration and the impact of both markers of haemostasis on the severity of subclinical atherosclerosis. PMID: 28749986
- TF is highly expressed in breast neoplasms, but does not predict survival or correlate with tumor size. PMID: 28551673
- Inhibition of the inflammatory signaling intermediate p38 MAPK reduced tissue factor (TF) mRNA by one third but increased tumor necrosis factor (TNF) and interleukin-1 beta (IL-1beta) mRNA. PMID: 28343272
- TF levels were significantly elevated in type 2 diabetes mellitus (both with and without cardiovascular complications) when compared to the controls. We suggest that pathologic plasma TF activity, as marker of increased propensity of clot pathology, should be investigated. PMID: 28246677
- our data show that a few select TF residues that are implicated in interacting with PS contribute to the TF coagulant activity at the cell surface. However, our data also indicate that TF regions outside of the putative lipid binding region may also contribute to PS-dependent decryption of TF. PMID: 27348126
- These findings suggest that cancer cell-derived extracellular vesicles mediate coagulopathy resulting in ischemic stroke via TF-independent mechanisms. PMID: 27427978
- Macrophage tissue factor prothrombotic activity is regulated by integrin-alpha4/arf6 trafficking. PMID: 28495929
- this study shows that low levels of circulating tissue factor may contribute to the reduced coagulopathy reported in patients infected with Neisseria meningitidis lpxL1 mutants PMID: 28024455
- Oligoubiquitination of Lys255 within TF permits PP2A to bind and dephosphorylate Ser253 and occurs to terminate TF release and contain its activity. PMID: 27599717
- Circulating miR-126 exhibits antithrombotic properties via regulating post-transcriptional TF expression, thereby impacting the hemostatic balance of the vasculature in diabetes mellitus. PMID: 27127202
- Data suggest that CAIX (carbonic anhydrase IX) is a novel downstream mediator of asTF (alternatively spliced tissue factor) in pancreatic ductal adenocarcinoma, particularly under hypoxic conditions that model late-stage tumor microenvironment; tumor hypoxia appears to lead to up-regulation of CAIX expression (or 'activation'), which is more pronounced in tumor cells overexpressing asTF. PMID: 27721473
- Low concentrations of TF and exogenous FXIa, each too low to elicit a burst in thrombin production alone, act synergistically when in combination to cause substantial thrombin production. PMID: 27789475
- In placenta of patients with preeclampsia, we detected abnormal expression of F3 and THBD with increased protein and mRNA levels. The role of these molecules in the pathogenesis of this disease and in alterations of hemostatic and histopathological aspects of placentas need further studying. PMID: 27002259
- These findings suggest that activation of TF-pathway is an important component of dengue virus-related coagulation disorders. PMID: 27592310
- in tumor microenvironment, TF-induced coagulation activated the complement system and subsequently recruited myeloid-derived suppressor cells to promote tumor growth. PMID: 28106852
- Hypoxia increased the expression of TF in human podocytes NF-kappaB dependently. TF may have a critical role in the hypoxic podocyte injury. PMID: 26715508
- These results reveal a functional link between VWF and TF under whole blood flow conditions, in which surface-immobilized TF and VWF mutually contribute to mural thrombus formation, which is essential for normal hemostasis. By contrast, TF circulating in blood may be involved in systemic hypercoagulability, as seen in sepsis caused by severe microbial infection, in which neutrophil inflammatory responses may be active. PMID: 27562418
- TF expression significantly correlated with levels of CRP, TNF-alpha and MCP-1. These factors may play an important role in the development of chronic thromboembolic pulmonary hypertension. PMID: 26667361
- Microvesicle-associated tissue factor procoagulant activity, but not plasma TF antigen, may provide valuable additional information for the diagnostic work-up of women with suspected ovarian cancer. PMID: 26967531
- This brief review summarizes the contribution of the coagulation system and in particular the role of TF in brain hemostasis as well as to the pathophysiology of stroke and multiple sclerosis. [review] PMID: 27207429
- stimulated von Willebrand factor secretion by umbilical vein endothelial cells PMID: 27766025
- Circulating FVII, FVIIa and TFPI were significantly elevated in women with severe preeclampsia in the absence of comparable changes in plasma TF levels. PMID: 26765308
- The data obtained indicate that active tissue factor, TF is present in membrane microparticles produced in vitro by endothelial cells, monocytes, and THP-1 cells, but not in microparticles derived from granulocytes and platelets. PMID: 27260391
- Results indicate that granulocyte-colony stimulating factor receptor, tissue factor, and vascular endothelial growth factor receptor bound vascular endothelial growth factor expression as well as their co-expression might influence breast cancer biology. PMID: 27629739
- the actin-binding protein filamin-A has a critical role in incorporation of Tissue factor into extracellular vesicles and secretion of extracellular vesicles from ovarian cancer cells exposed to hypoxia PMID: 26446354
顯示更多
收起更多
-
亞細(xì)胞定位:[Isoform 1]: Membrane; Single-pass type I membrane protein.; [Isoform 2]: Secreted.
-
蛋白家族:Tissue factor family
-
組織特異性:Lung, placenta and pancreas.
-
數(shù)據(jù)庫(kù)鏈接:
Most popular with customers
-
-
YWHAB Recombinant Monoclonal Antibody
Applications: ELISA, WB, IHC, IF, FC
Species Reactivity: Human, Mouse, Rat
-
Phospho-YAP1 (S127) Recombinant Monoclonal Antibody
Applications: ELISA, WB, IHC
Species Reactivity: Human
-
-
-
-
-